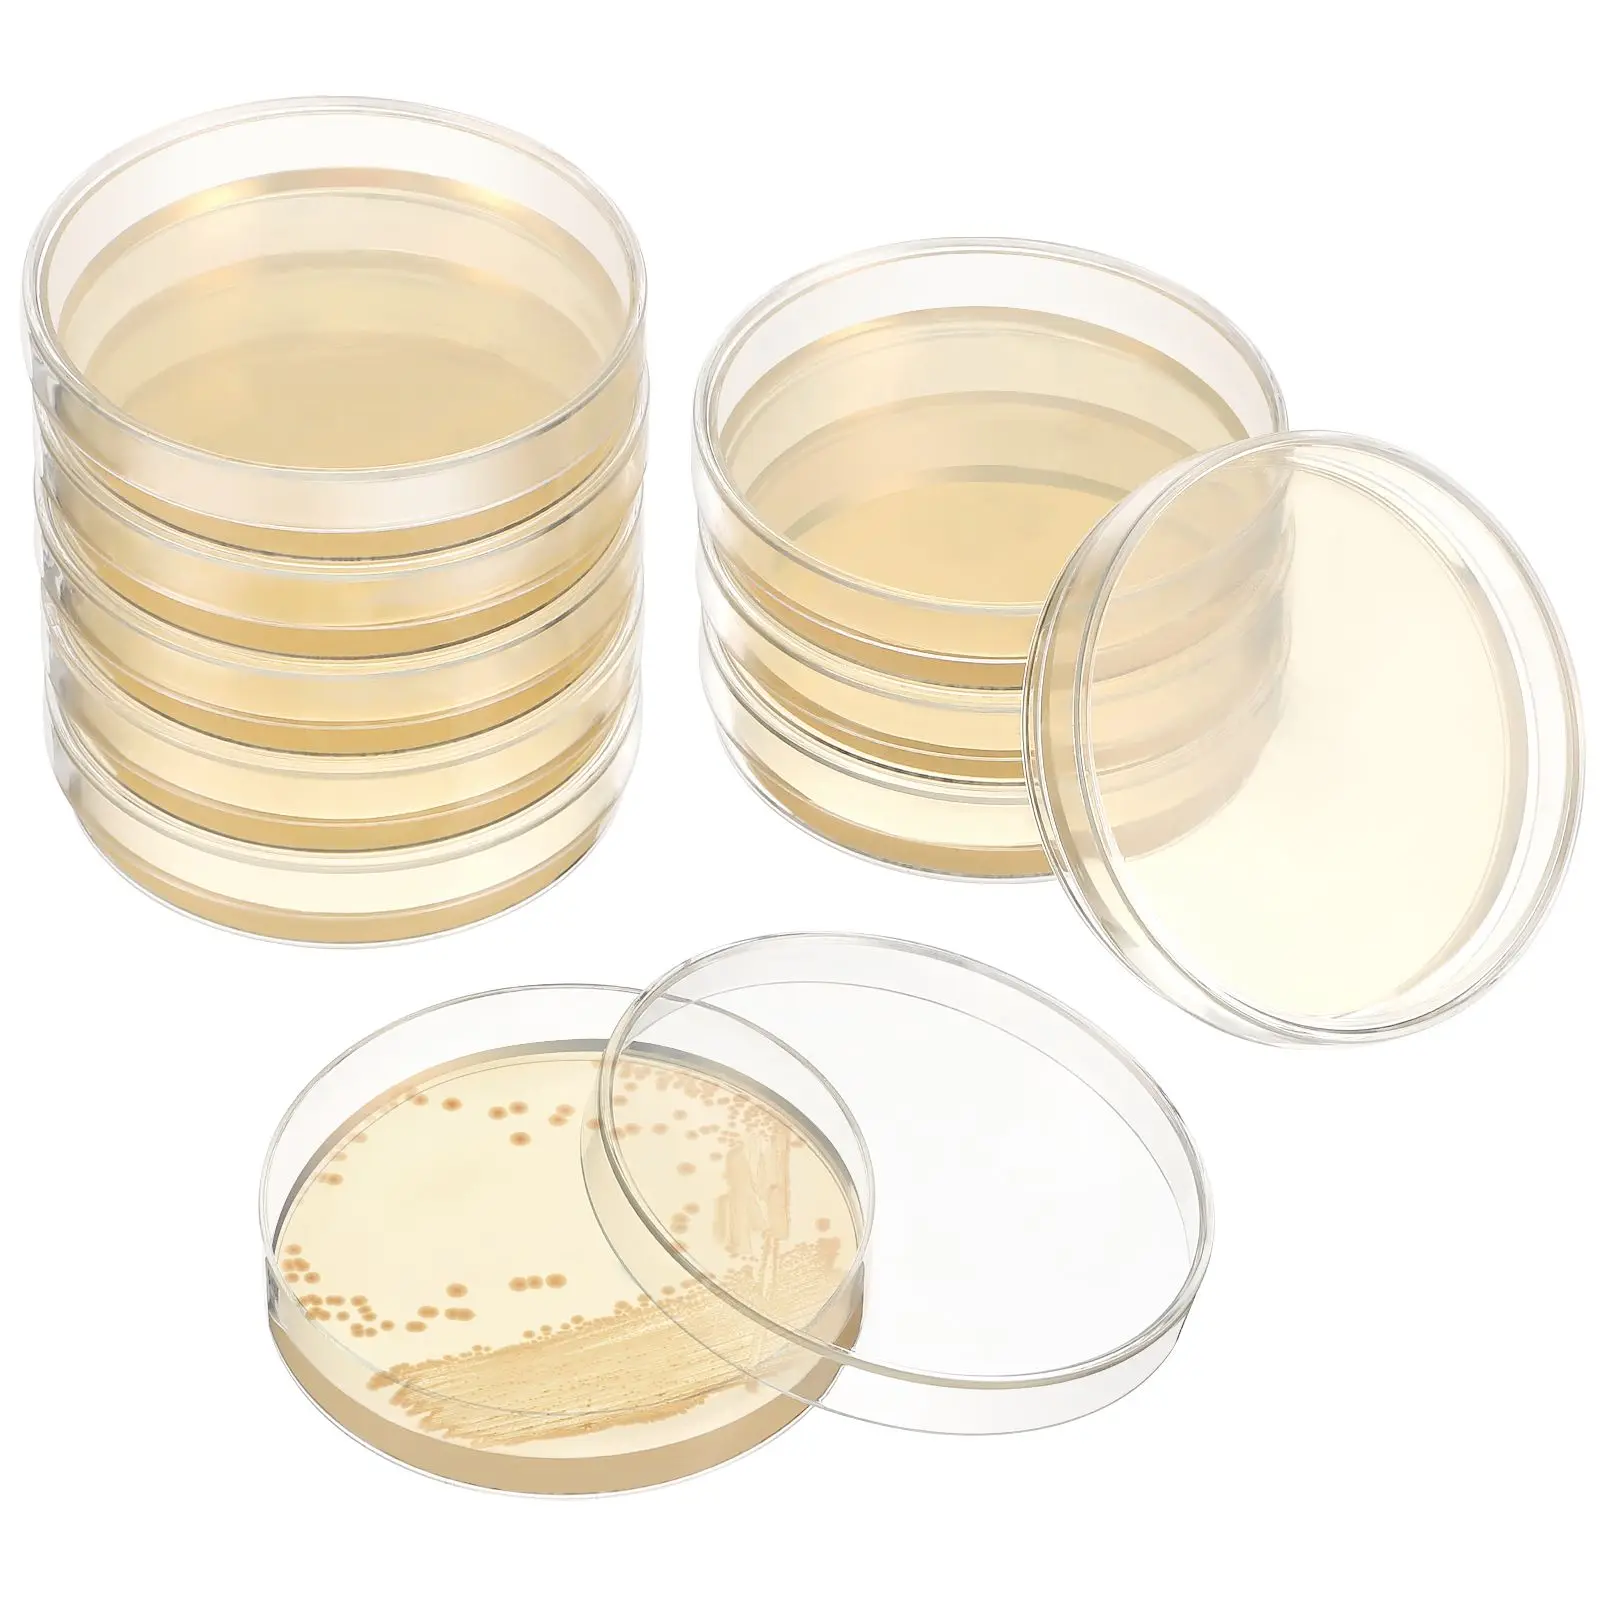

2024 Новая портативная игровая консоль X9 с 3,5-дюймовым IPS-экраном, мини-видеоигровая машина с более чем 10000 играми, 11 эмуляторов, ретро-игровой плеер 2000mAh


Home Textile Home Decoration
артикул: 67399c4aafb0d40177d56fab
14,050.00 руб.-3%
13,629.00 руб.
Доставка из: Россия
График изменения цены & курс обмена валют
Пользователи также просматривали

684.35 руб.
New Portable Titanium Alloy Keychain Ultra-light 360° Rotatable Car Key Ring Brass Keychain Outdoor Small Tool
aliexpress.com
1,450.99 руб.
10Pcs 16X3.0Mm-30° Inserts Cutters Replacement For Lathe Wood Turning Finisher Hollower Tool Lathe Tools And Accessories
aliexpress.com
1,885.23 руб.
Women’s Wedge High Heel Peep Toe Sandals Leopard Platform Sandals Ladies Thick Sole Summer Shoes Espadrilles Zapatillas Mujer
aliexpress.com
2,087.28 руб.
Unassembled Miniature Dollhouse DIY Kit, Dollhouse Building Kit with Dustproof Cover for Shelf Living Room Decor Collection
aliexpress.com
1,465.66 руб.
20 Pcs Agar Plates For Laboratory Nutrient Agar Plates Petri Dishes for Laboratory Experiment Supplies Science Teaching
aliexpress.com
1,670.97 руб.
Spring Men's Slim Fit Tactical Pants, Sports And Leisure Hunting Work Pants, Men's Outdoor Camping, Hiking And Combat Pants
aliexpress.com
1,428.18 руб.
Glitter Gold Cherry Keychain Cherries Pendant for Coach Handbag Shoulder Bags Women's Bag Charm Accessories Gift
aliexpress.com
2,347.17 руб.
Folding Knife Portable Pocket Knife Damascus Steel Blade Wooden Handle for Outdoors Camping Survive EDC Tool
aliexpress.com
4,779.08 руб.
Autumn Winter Fashion Ladies Cotton Padded Jacket Women Jackets Loose Solid Casual Coats Oversized Warm Belt Puffer Jackets
aliexpress.com
2,194.01 руб.
Multi-Surface Brush Rolls Replacement Parts For Byissell Crosswave 1785 2303 Vacuum Cleaner, For Bissell Crosswave 3In1 Accessor
aliexpress.com
2,547.59 руб.
For Land Rover Range Rover Evoque 2012-2015 Right Car Rear Lamp Tail Lamp Cover Lamp Shell Lampshade Shell
aliexpress.com
2,271.41 руб.
Nano Eye Mist Sprayer & Eye Wash Kit, Portable Eye Mister for Eyelid to Relief Dry Eyes, Rechargeable Eye Steamer for Eye Drops
aliexpress.com
349.51 руб.
M2 Hot Melt Inlaid Copper Nut, Injection Nut, SL Double Twill Knurled Injection Molded Brass Nut, Copper Thread Inlaid Nut100Pcs
aliexpress.com
600.44 руб.
Custom Stitch Cute Volleyball Biker Workout Shorts for Women Gym Athletic Yoga Shorts
aliexpress.com
282.70 руб.
Mens Mensa Club Logo Halloween Anime Designing Wholesale Middle Aged Cheap Sale Autumn Casual Fitness Pillow Case
aliexpress.com
330.77 руб.
USB Motorcycle Charger Port Stable Type C Phone Charger Safe Power Adapter Waterproof Design For Telephones Tablets Motorcycle
aliexpress.com
2,588.33 руб.
Pizza Stone Brush Pizza Oven Grill Brush 58.66 Inches Heat-Resistant Barbecue Grill Clean Tool With Scraper Commercial Cooking
aliexpress.com
165.39 руб.
Masquerade Props Dress Up Halloween Mask Hat Cosplay Figure Cosplay Mask Face Cover Funny Anime Cosplay Props Party Stage Prop
aliexpress.com
1,224.51 руб.
3600Mah BOPL4100 Mobile Phone Battery Long-Lasting Performance For Htc Desire 526 526G 526G+ Dual Sim D526h Premium Replacement
aliexpress.com
699.83 руб.
Sparkling Rose Gold Pink Daisy Rose Family Tree Hearts Charm Beads Fit Original European 925S ilver Bracelet DIY Women Jewelry
aliexpress.com
2,365.91 руб.
Aigo P Wireless Keyboard and Mouse Combo 2.4G USB Silent Keyboard and Mouse Full-Size Slim Keyboard & Mouse Set For Windows Mac
aliexpress.com
526.30 руб.
Transparent 16-Grid Earrings Necklace Storage Box Compact 2-Tier Jewelry Organizer Lightweight Space Saving Drawer Design
aliexpress.com
2,698.31 руб.
Motorcycle Accessories Adjustable Extendable Brake Clutch Lever Handbar For YAMAHA FZ 700 FZ700 GENESIS 1987 87 CNC Aluminum fz
aliexpress.com
1,996.85 руб.
High Waist Pants Plus Size 3XL 4XL Ruffles Green Wide Leg Capris Office Lady Casual Business Long Trousers for Women Autumn 2023
aliexpress.com
12,220.62 руб.
Cosplay Hanfu Western Region Style Chinese Traditional Dress Woman Improved Tang Dynasty Hanbok Girl Fairy Princess Costume
aliexpress.com
599.62 руб.
Binance Coin Cryptocurrency Miners TShirt For Men Futures Soft Leisure Tees T Shirt Trendy Fluffy
aliexpress.com
1,279.09 руб.
Geebro Girl Winter Tie Dye Berets French Classic Knitted Soft Hats Women Warm Soft Painter Caps Female Vintage Beret Bonnet
aliexpress.com
1,188.66 руб.
DIY Diamond Painting Muslim islam ramadan religious art Diamond Mosaic Full Drill Square Embroidery round Handmade Hobby5 pcs
aliexpress.com
3,666.19 руб.
Freeshipping FP40R12KT3 FP25R12KT3 FP50R12KT4 FP35R12KT4-B15 FP25R12KT4 IGBT module
aliexpress.com
4,333.43 руб.
women spring solid sweatshirt long sleeve v neck thin sweatshirts sun protection button up knitted sweatshirt y, Black
dhgate.com
1,768.73 руб.
men's pants corduroy pants loose middle-aged joggers middle-aged men dad installed in autumn and winter men's casual pants corduro, Black
dhgate.com
4,760.34 руб.
suit women's floral printed blouse long sleeve 100% cotton single breasted prairie chic female shirt, White;black
dhgate.com
1,352.94 руб.
Изолят сыворочного протеина BioTech USA "ISO WHEY Zero lactose" Ваниль-корица (500г)
rozetka.com.ua
455.84 руб.
stud maikale simple clover earrings gold color plated butterfly hook hanging for women accessories classic jewelry gift, Golden;silver
dhgate.com
2,391.83 руб.
мужская o-образный вырез пятница 13 джейсон ужастик персонажи футболка hip hop for men топ tee s-6xl спорт с капюшоном hoodie
dhgate.com
2,391.83 руб.
nine inch grails для защиты дизайн хэллоуин пасха кролик tops скидка череп письмо версия для печати спорт толстовка с капюшоном толстовка фу
dhgate.com
3,290.78 руб.
дизайнеры балахона death череп скелет coffin косого ожерелье кольцо наклейка заплата выполненного на заказ футболки толстовки
dhgate.com
2,543.52 руб.
Clip Fan For Stroller USB Charging Fan Attachment For Stroller Power Bank 3 Speed Cooling Device Adjustable Stand For Seat Baby
aliexpress.com
1,702.74 руб.
A69egas Oven Pulse Ignition Controller Oven Lighter Pulse Igniter Universal Catering Gas Oven Spare Parts
aliexpress.com
1,587.87 руб.
2024 African Female Turban Cap Women's Autogele Headtie Nigeria Raw Silk Fan Gele Wedding Party Head Wraps Headwear Turbante
aliexpress.com




